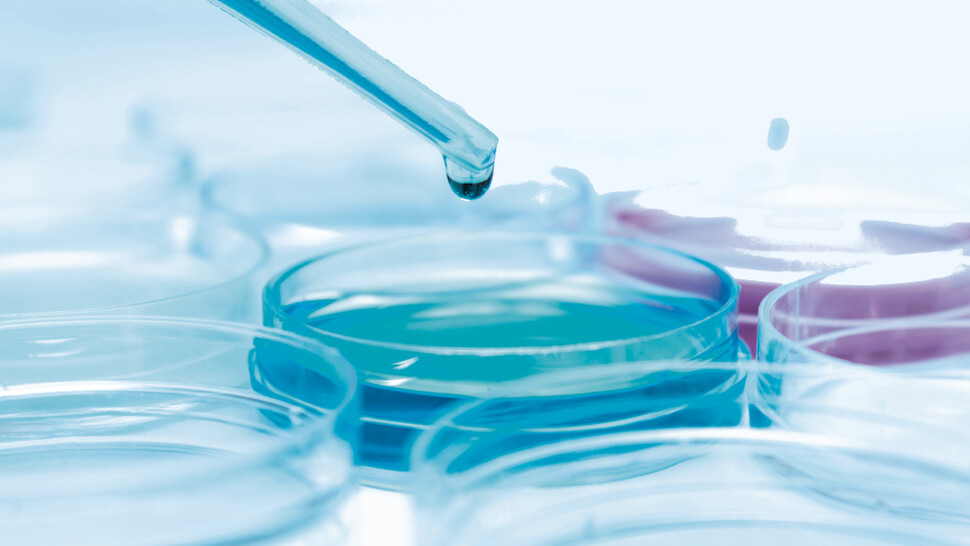

DRAABE PerPur
Produziert reines Wasser, frei von Mineralien, Verunreinigungen, Bakterien und Keimen, um höchste Hygienestandards zu gewährleisten und Rückstände und Kalkablagerungen zu verhindern.

Direkt-Raumluftbefeuchter werden gezielt dort eingesetzt, wo die Luftfeuchte benötigt wird. Für jede Anwendung und Raumgröße, ideal zur Nachrüstung, energieeffizient und wartungsfreundlich.
Hier kostenloses Infopaket anfordern und gratis Thermo-Hygrometer zur Messung Ihrer Luftfeuchte sichern!
Wir freuen uns auf Ihre Nachricht und Ihre Wünsche zur Direkt-Raumluftbefeuchtung für Ihre Anwendung.
Hier erhalten Sie weitere Informationen oder eine persönlichen Beratung.
Hier geht es zu unserem Kontaktformular Condair Direkt-Raumluftbefeuchtung
Hier finden Sie den Berater für Ihre Region zur Condair Direkt-Raumluftbefeuchtung